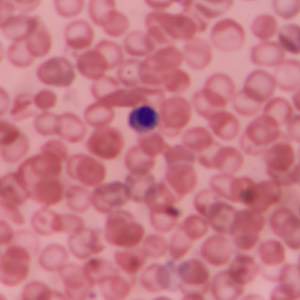

Comprometidos con la salud de México
En Comercializadora Medmont estamos comprometidos con la salud de la población y ofrecemos una amplia gama de medicamentos especializados genéricos y de patente con alta eficacia, para las siguientes áreas médicas: Oncología, Hematología, Reumatología, Nefrología, Urología, Endocrinología, Neumología, Anestesiología y Línea de Controlados. Contamos con una extensa red de proveedores confiables y reconocidos a nivel nacional e internacional, lo que nos permite ofrecer a nuestros clientes medicamentos de alta calidad a precios competitivos.
Nuestro equipo de profesionales altamente capacitados y comprometidos está siempre dispuesto a ofrecer el mejor servicio y atención personalizada, buscando cumplir con las necesidades específicas de cada cliente. Nos esforzamos por garantizar la disponibilidad constante de los productos y una entrega oportuna y confiable, lo que nos ha permitido establecernos como uno de los principales proveedores de medicamentos especializados en el mercado nacional.
Además, trabajamos en estrecha colaboración con médicos y especialistas de diversas áreas para asegurarnos de estar siempre actualizados y en línea con las últimas tendencias y avances médicos en cada una de las especialidades que atendemos. Nos enorgullece poder decir que somos una empresa confiable y comprometida con la calidad y la excelencia en el servicio, ofreciendo a nuestros clientes una experiencia de compra segura y satisfactoria.
Si buscas una empresa de confianza para la adquisición de medicamentos especializados genéricos y de patente en las áreas de Oncología, Hematología, Reumatología, Nefrología, Urología, Endocrinología, Neumología, Anestesiología y Material de Curación, no dudes en contactar con nosotros. En Comercializadora Medmont estamos a tu disposición para ofrecerte un servicio de alta calidad, atención personalizada y precios competitivos.